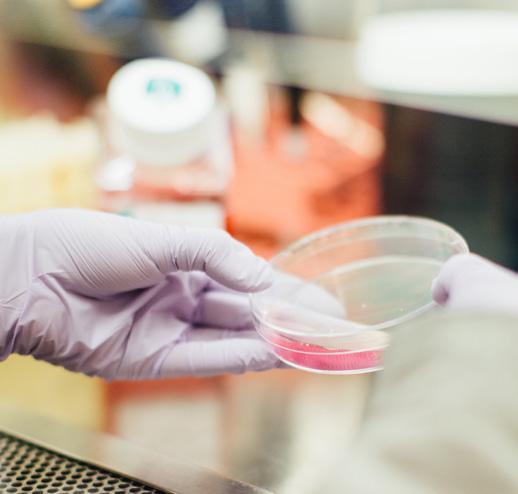

Développé


![]()
Développé


Dr. Rath Health Programs B.V.
Postbus 657 | 6400 AR Heerlen | Pays Bas
Fax: 0031 - 457 111 119 info@rath-programs.com www.dr-rath.com
* L’Office Américain des brevets et des marques a reconnu des combinaisons de micronutriments spécifiques développées dans notre institut de recherche. C’est la première fois que l’efficacité biologique de formulations de micronutriments spécifiques sur les systèmes cellulaires du corps humain est officiellement confirmée. Pour que les brevets respectifs soient accordés, il était nécessaire de prouver l’efficacité de chaque ingrédient par un travail scientifique minutieux. La reconnaissance de nos recherches par un organisme gouvernemental américain a des implications pour l’ensemble du domaine de la santé naturelle fondée sur la science.
BIENVENU CHEZ DR. RATH HEALTH PROGRAMS
DR. RATH – FONDATEUR DE LA MÉDECINE CELLULAIRE
LA SANTÉ COMMENCE AU NIVEAU DE LA CELLULE
DES PRODUITS TESTÉS SCIENTIFIQUEMENT
NOS FORMULES : NATURELLEMENT BREVETÉES
LA SIGNIFICATION DES SYNERGIES DE MICRONUTRIMENTS
LA VITAMINE C, UN INGRÉDIENT PRINCIPAL DES FORMULES DU DR. RATH
QUALITÉ DU PROGRAMME DE MICRONUTRIMENTS
CELLULAIRES DU DR. RATH
INFORMATIONS IMPORTANTES SUR LES INGRÉDIENTS ET LES ADDITIFS
APPORT RECOMMANDÉ
L’ALIMENTATION – UNE SOURCE APPROPRIÉE DE MICRONUTRIMENTS CELLULAIRES?
LES TÂCHES ET OBJECTIFS DE NOTRE TRAVAIL
NOTRE PROJET DE JARDIN SCOLAIRE EN AFRIQUE
L’ABONNEMENT AUX MICRONUTRIMENTS CELLULAIRES
LE PROGRAMME DE PARTENARIAT
Cette brochure fournit des informations sur le programme de micronutriments cellulaires du Dr. Rath, qui offre une variété de formulations de micronutriments innovantes et ciblées pour la supplémentation quotidienne. Notre société, la Dr. Rath Health Programs, se distingue des autres sociétés de vitamines par le fait qu’elle est entièrement détenue par une fondation à but non lucratif. Nous utilisons les bénéfices des ventes de nos programmes de micronutriments pour financer, en particulier, la recherche dans le domaine de la santé naturelle scientifiquement fondée et la diffusion mondiale des résultats de cette recherche. Nos compléments alimentaires sont développés selon les dernières découvertes scientifiques et sont même brevetés. C’est un fait unique au monde. Nous espérons que les pages suivantes vous convaincront du caractère unique de nos compléments alimentaires. En achetant ces produits, vous nous permettez de vous conseiller et de vous soutenir dans l’un des domaines les plus importants de votre vie : votre bien-être physique et votre santé.
Nous vous recommandons de consulter un thérapeute ou un conseiller qualifié pour déterminer vos besoins individuels en matière de santé. Appelez gratuitement notre équipe de service si vous avez des questions ou si vous avez besoin d’aide. Obtenez des conseils individuels sur vos objectifs de santé personnels sans aucune obligation - cela ne vous coûtera rien, si ce n’est un peu de votre temps !
Nous nous ferons un plaisir de vous conseiller entre 8h30 et 17h du lundi au vendredi sur notre hotline gratuite*.
France : 0800 – 91 94 03
Belgique : 0800 – 76 750
Suisse : 0800 – 84 81 33
Luxembourg : 800 – 27 44 9
*Certains opérateurs de téléphonie mobile peuvent facturer des frais.
Nous nous réjouissons de votre appel. Cordiales salutations
Votre équipe Dr. Rath

La société Dr. Rath Health Programs B.V. est l’une des rares entreprises spécialisées dans la recherche sur les micronutriments et le développement de suppléments nutritionnels qui portent le nom d’un scientifique. Et pour une très bonne raison. Le Dr. Rath a découvert que les décisions concernant la santé et la maladie sont prises au niveau des cellules. Les maladies courantes telles que les crises cardiaques, les accidents vasculaires cérébraux et le cancer sont la conséquence d’une carence chronique en vitamines, minéraux, acides aminés et autres micronutriments – également connus sous le nom de micronutriments cellulaires – dans des millions de cellules du corps. Si suffisamment de micronutriments sont livrés aux cellules les maladies peuvent être évitées. Le Dr. Rath a inventé l’expression «Médecine Cellulaire» pour décrire cette découverte. Le Dr. Rath était un scientifique associé et ami personnel du Dr. Linus Pauling, double lauréat du prix Nobel. Ensemble, ces deux scientifiques ont publié plusieurs articles de recherche pionnière sur le rôle des micronutriments dans la prévention des troubles cardiovasculaires. Après la mort de Pauling en 1994, le Dr. Rath et son équipe de scientifiques de l’institut de recherche qu’il a fondé ont systématiquement continué à développer des recherches sur les vitamines. Les découvertes révolutionnaires du Dr. Rath dans le domaine de la santé naturelle ont en même temps jeté les bases de combinaisons novatrices de substances naturelles, comme celles disponibles dans le Programme de Micronutriments Cellulaires du Dr. Rath.
Si vous savez comment votre corps fonctionne, vous savez aussi pourquoi vous vous sentez parfois en forme et parfois apathique, pourquoi vous êtes en bonne santé mais pouvez tomber malade.
Votre santé dépend de la plus petite unité de votre corps : la cellule. Examinons-la de plus près.
• Notre corps est composé de milliards de cellules, les plus petites unités vivantes de notre organisme. Leur fonction décide de la vigueur que nous, les humains, ressentons.
• Si une cellule ne fonctionne pas, l‘organe - et par conséquent le corps - ne peut pas fonctionner correctement. Dans ce cas, pour faire simple, la cellule a faim - elle manque de micronutriments.
• La capacité de performance et la maladie se décident au niveau de la cellule : si la cellule souffre de carences, elle cesse partiellement ou totalement de fonctionner, tombe malade et/ou meurt.
Le point commun de toutes les cellules est qu‘elles doivent être alimentées en micronutriments pour remplir leurs fonc-
tions de manière optimale. Notre alimentation est donc d‘une importance fondamentale pour la vitalité et le bien-être.
Outre l‘oxygène, l‘eau et ce que l‘on appelle les „macronutriments“ – protéines, glucides et lipides – ce sont surtout les micronutriments cellulaires qui pilotent les processus cellulaires importants pour la vie.
La plupart des micronutriments cellulaires sont responsables de l’accélération de milliers de réactions biochimiques dans le métabolisme de chaque cellule, ou les rendent possibles en premier lieu. La structure, la protection, l’approvisionnement en énergie et le fonctionnement de nos cellules et de nos organes - et finalement de notre corps - sont directement liés aux micronutriments cellulaires. Corps
La santé se décide au niveau cellulaire
Cellules
Cellules musculaires
Cellules de la paroi des vaisseaux
Cellules nerveuses
Cellules du foie
Érythrocyte Plaquettes Lymphocyte
Cellules sanguines
Cellules du tissu conjonctif

Une alimentation saine et équilibrée avec un large choix de fruits et légumes frais et biologiques constitue la base pour un apport de micronutriments à notre corps. Nos formules complètent cette sélection de nutriments avec des vitamines, des minéraux, des oligo-éléments et une gamme d’autres ingrédients bénéfiques pour la santé. Elles soutiennent le métabolisme global et apportent une contribution précieuse aux soins de santé de base à tout âge.
En optant pour notre gamme de micronutriments, vous faites un bon choix. Vous achetez des produits qui sont tout à fait différents de la plupart des suppléments nutritionnels habituellement présents sur le marché, car ils ont été développés et leur efficacité testée sur la base de la recherche scientifique.

Dr. Rath Vitacor Plus™
Formule de base pour la supplémentation nutritionnelle quotidienne
Vous pouvez obtenir ce produit et de nombreux autres sur notre boutique en ligne à www.dr-rath.com – facile d’accès via le code QR.
Une condition préalable essentielle pour pouvoir vous offrir des produits de la plus haute qualité avec des avantages prouvés est notre étroite collaboration avec le Dr. Rath Research Institute, un établissement international de premier plan dans le domaine de la santé naturelle basée sur la science.
La plupart des entreprises du secteur des suppléments nutritionnels ne réalisent pas d’études scientifiques ou cliniques propres. Elles s’appuient en fait sur des publications tierces (y compris la nôtre) pour fournir des preuves de l’efficacité présumée de leurs produits.
Vous pouvez accéder aux études ici : www.drrathresearch.org

Dr. A. Niedzwiecki, directrice de l’Institut de Recherche du Dr. Rath depuis plus de 20 ans, et un scientifique international de premier plan dans le domaine de la recherche sur les micronutriments.
L’institut de Recherche du Dr. Rath est considéré comme un pionnier dans le domaine de la recherche scientifique en santé naturelle, car nous avons été les premiers à soumettre notre gamme de suppléments nutritionnels à des recherches approfondies au niveau cellulaire et de l’organisme entier. Les résultats de nos propres recherches menées par l’équipe autour du Dr. Rath et du Dr. Niedzwiecki pendant plus de 10 ans ont été publiés dans de nombreuses revues scientifiques indépendantes.
Depuis plus d’une décennie, nos scientifiques étudient l’efficacité, l’innocuité et les avantages des synergies de micronutriments dans le contrôle naturel de divers processus pathologiques. Notre objectif est de faire des remèdes naturels fondés sur la science une partie importante d’un système de santé axé sur le patient dans tous les pays du monde.
Comme notre entreprise de vitamines et l’Institut de Recherche du Dr. Rath appartiennent à une fondation caritative, vous ne soutenez pas seulement votre santé en achetant nos produits. Vous contribuez également à la poursuite de notre engagement de trois décennies envers les thérapies naturelles et la santé humaine.

L’Institut de Recherche du Dr. Rath en images
L’Office américain des brevets et des marques, une agence gouvernementale américaine, a officiellement reconnu l’efficacité de nos combinaisons de micronutriments scientifiquement développées. A ce jour, nous sommes la première et la seule organisation au monde à breveter systématiquement ses développements dans la recherche sur les micronutriments, garantissant ainsi qu’ils sont fondés sur des preuves scientifiques. Les implications de cette stratégie sont considérables: dans le monde entier, pour la première fois, des problèmes de santé courants et graves peuvent être évités de manière naturelle, sûre et efficace. À long terme, cela réduira les maladies courantes à une fraction de leur incidence actuelle.
En savoir sur nos formules brevetées : Les effets biologiques des combinaisons de micronutriments que nous avons étudiées et testées ont été brevetés dans de nombreux domaines.
Pour chacun de ces brevets, un grand nombre d’études scientifiques ont dû être documentées pour prouver à la fois la composition spécifique des vitamines et autres micronutriments, et l’efficacité biologique de ces combinaisons.

YouCell™-IQ
Technologie brevetée pour le soutien de la fonction cognitive Article n° 049

COMPRENNENT :
• Relaxation naturelle de la paroi des vaisseaux sanguins
• Abaissement naturel de la glycémie et stimulation de la production d’insuline
• Inhibition naturelle de la prolifération des cellules cancéreuses
• Protection naturelle de la fonction oculaire contre les dommages oxydatifs

Relavit™
Technologie brevetée pour la relaxation naturelle de la paroi des vaisseaux
Article n° 0005

Diacor™
Technologie brevetée pour la réduction naturelle de la glycémie et la stimulation de la production d’insuline
Article n° 0007

YouCell™-V
Technologie brevetée pour l‘inhibition naturelle des portes d‘entrée du coronavirus
Article n° 048
• Protection naturelle de l’équilibre hormonal
• Soutien naturel de la santé des os
• Soutien naturel contre les bactéries
• Soutien naturel du système immunitaire
• Soutien naturel de la fonction cognitive
• Un soutien naturel contre les virus

EpiQuercican™
Technologie brevetée pour l’inhibition naturelle de la prolifération des cellules cancéreuses
Article n° 019

Osteoforte™
Technologie brevetée pour le soutien de la santé osseuse
Article n° 0027

Lensivit™
Technologie brevetée pour protéger naturellement la fonction oculaire des dommages oxydatifs.
Article n° 047

Femicell™
Technologie brevetée pour le soutien de l’équilibre hormonal
Article n° 0016

Dr. Rath’s
Phytobiologicals™
Royal Complex
Technologie brevetée pour aider en cas d‘infections bactériennes
Article n° 035

Dr. Rath Immun Complex plus
Technologie brevetée pour soutenir le système immunitaire
Article n° 045
Les vitamines, minéraux, acides aminés et autres micronutriments ne sont jamais présents dans la nature seuls ou isolément. Ils sont liés ensemble dans les cellules de notre corps comme un réseau, l’efficacité optimale d’un micronutriment individuel dans ce réseau dépendant de la présence d’autres micronutriments et composants nutritionnels. Ce n’est qu’en combinaison que ces substances peuvent atteindre leur pleine efficacité.
Les effets mutuellement bénéfiques que les substances ont les unes sur les autres n’améliorent pas seulement leurs propres avantages.
Ils permettent également à d’autres micronutriments d’être mieux absorbés et utilisés par les processus métaboliques.
En appliquant le principe de synergie, nous pouvons obtenir cet effet maximal avec nos formulations de micronutriments sans recourir à des mégadoses d’un micronutriment individuel.
Vous souhaitez en savoir plus? Demandez notre brochure gratuite «Produits uniques de santé» (référence de l’article n° 63041).

La vitamine C est probablement la plus connue de toutes les vitamines – et pour cause: presque aucune autre vitamine ne remplit autant de fonctions différentes dans le corps. Une forme importante de vitamine C est la vitamine C tamponnée. Elle se forme lorsque l’acide ascorbique est combiné avec un minéral (normalement du calcium, du magnésium ou du potassium). La vitamine C tamponnée est plus douce pour l’estomac que l’acide ascorbique pur qui peut causer des maux d’estomac chez les personnes sensibles. La vitamine C tamponnée est également mieux absorbée par le corps.

Le palmitate d’ascorbyle est une forme particulièrement efficace de vitamine C. Cependant, en raison de son coût élevé, il est rarement utilisé dans les suppléments nutritionnels. Le palmitate d’ascorbyle est liposoluble, et peut donc être intégré dans les membranes cellulaires et d’autres structures cellulaires riches en lipides, et protéger ces structures contre l’oxydation.

La composition scientifique des formules du Dr. Rath est ce qui rend notre programme de suppléments nutritionnels différent des autres. La haute qualité de nos produits démontre la responsabilité que nous avons envers votre santé.
Nos produits sont :
• exempts de matériel végétal génétiquement modifié
• exempts de colorants et d’arômes artificiels
• sans allergènes tels que le gluten*, le lactose et le blé
• sans gélatine (à la place, nous utilisons, par exemple, de l’hypromellose dérivée de fibres cellulaires végétales)
• sans levure et MSG (glutamate monosodique)
• exempt d’acides gras trans
* Exception: la formule de fibres alimentaires Dr. Rath’s Phytobiologicals™ Balance Control
Ingrédients d’origine naturelle :
Dans la mesure du possible, nous utilisons des ingrédients et des additifs d’origine naturelle tels que:
• Fruits, en particulier agrumes, papaye, ananas, pépins de raisin, noix de coco
• Autres plantes, notamment maïs, soja, betterave sucrière, thé vert, algues, soucis, extraits d’écorce de pin
• Chondroïtine et glucosamine (dans Arteriforte™) dérivées du cartilage naturel
En ce qui concerne les ingrédients, nous faisons la distinction entre les ingrédients actifs et les additifs.
Nos formules de micronutriments cellulaires se composent de nombreuses substances individuelles différentes qui travaillent ensemble pour aider à optimiser les fonctions cellulaires naturelles. Chaque substance individuelle contribue à l’effet, et la combinaison dans chaque produit est scientifiquement adaptée. Les vitamines, acides aminés, minéraux, extraits de plantes (« phytobiologiques ») et autres nutriments cellulaires sont spécifiés sur l’étiquette avec l’apport journalier respectif. « Actif » signifie également que nous utilisons des formes de nutriments cellulaires de haute qualité qui sont facilement absorbés et rapidement métabolisés. Cela distingue nos formules de haute qualité des produits d’imitation bon marché.
BIODISPONIBILITÉ
Pour permettre une absorption plus rapide et donc fournir une biodisponibilité optimale des micronutriments cellulaires à l’organisme, nos minéraux et oligo-éléments sont organiquement liés aux acides aminés glycine ou mé -
thionine. De cette façon, nous pouvons empêcher les micronutriments cellulaires individuels de se contrecarrer les uns les autres.
Un additif est une substance nécessaire à la production de la capsule/ gélule, mais qui ne contribue pas directement à l’effet. Un bon exemple est la saveur de citron dans la gélule Vitacor Plus, qui provient d’une source végétale naturelle. Nous prenons grand soin d’éviter les additifs inutiles ou douteux.

CONSOMMATION :
Prenez les formules de micronutriments cellulaires au cours de la journée, au moment des repas, avec beaucoup de liquide (eau, jus, thé). Cela garantit une concentration constante dans la circulation sanguine et une absorption uniforme des micronutriments par l’organisme, ainsi qu’une meilleure absorption des vitamines liposolubles E, D et du bêta-carotène.
Si vous prenez plus d’une formule par jour, vous pouvez prendre les gélules avec une collation.
DURÉE DE LA CONSOMMATION:
les soins de base de la santé de notre corps – par exemple sous la forme de la combinaison de base Vitacor Plus™
& Dr. Rath’s Phytobiologicals™ – devraient être une habitude régulière et à long terme. Tout au long de notre vie, des millions de cellules consomment l’énergie cellulaire que nous devons fournir à notre corps.
Pour plus d’informations importantes, consultez notre catalogue de produits gratuit «Programme de Micronutriments du Dr. Rath-Information sur les produits » (numéro d’article 20991).


Les aliments naturels tels que les fruits et légumes poussent principalement en monoculture, c’est-à-dire qu’un champ entier est recouvert d’un seul type de plante. Cela augmente le rendement et donne à l’agriculteur la possibilité de faire des profits sur ses produits.
Mais la conséquence des monocultures est que le sol est unilatéralement épuisé en raison des besoins spécifiques en micronutriments de la plante, et l’engrais doit être utilisé pour déclencher la croissance de la plante. Ceci est contraire à la régénération naturelle du sol, et la plante qui y pousse est maintenant appauvrie en micronutriments vitaux et sera peut-être incapable de créer l’immunité nécessaire pour la protéger des prédateurs et d’autres influences. Par conséquent, les produits phytopharmaceutiques doivent être utilisés.
De plus, la consommation de fruits et légumes frais n’a cessé de diminuer ces dernières années. La baisse de la teneur en micronutriments et la réduction de la consommation de produits naturels contribuent de plus en plus au fait que nous n’obtenons pas suffisam-
ment de micronutriments cellulaires de notre alimentation. Si la consommation de micronutriments cellulaires par les aliments est insuffisante, les suppléments nutritionnels peuvent combler ces lacunes et peuvent donc contribuer à prévenir les carences.
Réduction de la teneur en micronutriments à l’aide de carottes et de haricots comme exemples
Pertes 1985-2002
Nous travaillons sous l’égide d’une fondation, la Dr. Rath Health Foundation. Cela signifie que tous les bénéfices gagnés sont réinvestis dans d’autres recherches vitales et le travail d’éducation à la santé correspondant. La base de notre travail est la recherche sur les micronutriments cellulaires et leur signification pour la santé. La diffusion de ces connaissances devrait ouvrir la voie à une nouvelle forme de soins de santé basée sur des remèdes naturels efficaces et peu coûteux sans effets secondaires.
L’objectif primordial de notre travail est une stratégie de santé axée sur la prévention. Un système immunitaire fort n’est qu’un exemple d’un domaine dans lequel nous offrons des solutions naturelles et efficaces. Restaurer et maintenir la santé de millions de personnes partout dans le monde est notre priorité. Naturellement!
Un résumé de nos objectifs :
• Éducation à la santé
• Promouvoir des remèdes naturels basés sur la science
• Recherche et développement de suppléments nutritionnels progressifs
• La création d’un système de santé moderne basé sur la prévention



Le passage aux soins de santé préventifs ne peut se limiter à quelques pays riches et industrialisés. C’est pourquoi nous avons lancé le projet «Movement of life» en Afrique.
Dans le cadre du projet de jardin scolaire «Movement of Life», les enfants et les jeunes découvrent les bienfaits pour la santé des fruits et légumes cultivés sur le marché. Ils planifient et entretiennent les jardins scolaires, encouragent le jardinage communautaire dans les villages où vivent leurs familles et contribuent à améliorer la santé de régions entières.
Le succès de notre initiative de jardins peut être quantifié en chiffres : en Ouganda, en Afrique de l’Est, l’un des pays les plus pauvres du monde, plus de 12.000 arbres fruitiers ont été plantés depuis le début du projet en 2015. Depuis lors, plus de 100.000 personnes en Ouganda ont bénéficié directement du projet depuis lors (en juillet 2020).
En achetant l’un de nos produits, vous soutiendrez également le projet « Movement of Life » de la Dr. Rath Health Foundation en Afrique et contribuerez à améliorer des vies.
La santé pour tous signifie l’éducation pour tous.

Plus d’informations sur ce projet et d’autres projets du Movement of life peuvent être trouvées sur www.movement-of-life.org
Il suffit de scanner ce code QR.
Vous avez maintenant acquis un premier aperçu de notre groupe d’entreprises et appris ce qui rend les formules nutritives cellulaires du Dr. Rath si spéciales et précieuses. Vous avez appris des scientifiques derrière la recherche sur les micronutriments et la formulation des produits sur l’importance des synergies de micronutriments et leur effet positif sur les cellules du corps. Vous avez pu constater par vousmême les normes élevées que nous fixons pour la qualité de nos produits uniques. Vous avez acquis une impression du travail de notre fondation et de l’objectif majeur « Santé pour tous » basé sur l’exemple d’un projet de Movement of life.
Une fois que vous avez pris les micronutriments cellulaires pendant un certain temps et que vous vous êtes convaincu de leur valeur pour votre bien-être, nous vous recommandons fortement d’essayer notre abonnement aux micronutriments cellulaires.
Choisissez votre formule préférée et laissez-nous faire le reste. Nous vous livrerons automatiquement les produits de votre choix tous les deux mois. Il n’y a pas de frais de livraison, et vous recevrez deux mois d’approvisionnement à chaque fois, de sorte que vous ne serez jamais à court de votre formule préférée. Et si cela ne suffit pas à opter pour un abonnement : vos formules pour le 12ème mois seront un cadeau de notre part*.
Les avantages de votre abonnement :
• Produits gratuits au 12ème mois
• Ne plus payer les frais de livraison
• Pas de frais supplémentaires
• N’oubliez plus jamais de commander


* Avec des livraisons à intervalles de deux mois, la sixième livraison ne coûte aux abonnés que la moitié du prix. Ainsi, vous bénéficiez d‘un mois gratuit (à condition que l‘abonnement de l‘année en cours ne change pas). Nota Bene : pour mettre fin à l‘abonnement, vous devez l’annuler au moins 14 jours avant la date de livraison prévue. Dans ce cas le renouvellement de l‘abonnement n‘est possible que trois mois après la résiliation.
Maintenant que vous êtes un fan de nos produits de haute qualité testés scientifiquement, souhaitez-vous partager leurs avantages avec vos amis et votre famille? Vous pouvez facilement le faire grâce à notre programme de partenariat. Vous serez récompensé pour votre engagement, et vous n’aurez aucune obligation de commander pour vous-même, d’acheter en stocks ou d’atteindre des ventes minimales. Il vous suffit de vous inscrire et c’est parti : partagez les connaissances que vous avez acquises ou rapportez vos expériences avec nos produits de santé.

Sur notre site Internet, vous trouverez une vidéo explicative et de plus amples informations, par exemple sur notre offre éducative. Le lien se fait via le code QR suivant:


Appelez nous simplement si vous avez d’autres questions. Vous pouvez contacter notre équipe de service entre 8h30 et 17 h de lundi à vendredi sur notre hotline gratuite*.
France : 0800 – 91 94 03
Belgique : 0800 – 76 750
Suisse : 0800 – 84 81 33
Luxembourg : 800 – 27 44 9
*Certains opérateurs de téléphonie mobile peuvent facturer des frais.
Nous sommes ravis si nous avons suscité votre intérêt pour notre programme de micronutriments cellulaires et pour notre travail, et nous espérons que vous êtes satisfait de nos produits.
Cordiales salutations
Dr. Rath Health Programs B.V.
Postbus 657 | 6400 AR Heerlen | Pays Bas Fax: 0031 - 457 111 119 info@rath-programs.com www.dr-rath.com
